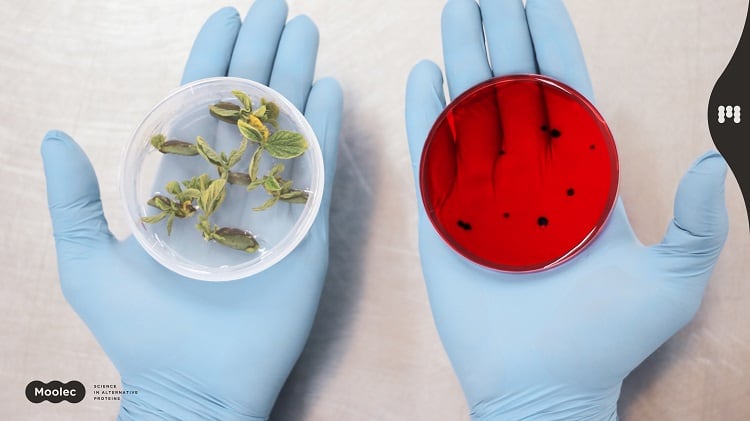

The trend for plant-based ingredients in food and beverage is on the rise. Swapping out synthetic compounds – such as colourants and aromas – for their ‘natural’ counterparts, however, means increasing reliance on traditional agricultural systems.
According to entrepreneur Tal Lutzky, therein lies a ‘major’ problem: whether sourced from animals or plants, the bioproduction of compounds is unsustainable and produces ‘very limited’ yields.
Producing compounds in this way is inefficient, Lutzky explained. It is responsible for a ‘major’ amount of organic waste and relies on excessive land, water, and fertiliser use.
Together with co-founder Amir Tiroler, Lutzky is taking a more sustainable approach to the production of biomolecules, he explained. The Israeli ag-tech company is leveraging transgenic modification and molecular farming techniques to produce high yields of natural compounds for the food industry.
Producing complex molecules in plants
Having completed agronomy studies at the Hebrew University of Jerusalem under the guidance of Professor Alexander Vainstein, Lutzky and Tiroler founded Pigmentum in 2018. Lutzky serves as CEO and Tiroler, CTO.
Their technology is founded on the inducible mechanism in transgenic plants. This means that the plant gene – which Pigmentum encodes to produce specific compounds – is ‘fully silent’ until the start-up deploys an external agrochemical signal.
“Our plants gain biomass and grow in natural, high rates,” Lutzky explained. “Only when we implement our agrochemical via an irrigation system or spraying do the plants respond with the hyperexpression of a specific desired compound. This is the core IP of Pigmentum.”
The technology enables the production of a wide range of compounds, including cytotoxic and complex compounds, which would otherwise be produced at ‘great’ difficulty and cost. Aside from proteins, Pigmentum is also working on metabolites such as pigments and aromas.
“We can also repress genetic elements, meaning we can stimulate the biosynthetic pathway towards a specific desired compound with minimum by-product.”
Pigmentum is working in both a laboratory and greenhouse setting in Northern Israel. At the molecular level, the cloning and engineering of plants, including growing it in tissue culture, occurs in the laboratory. It is then moved to a greenhouse for agrichemical activation.
“The biomass is then harvested, and the compound extracted from the tissue,” explained the co-founder.
Different methods are then applied depending on the final product. If it is a protein, for example, it will undergo a purification process. For a pigment, the process is ‘completely different’, we were told.
Pigments, aromas, and ‘lettuce milk’
Pigmentum is growing its compounds in romaine lettuce to produce high yields of natural compounds for the pharmaceutical, cosmetic, and food industries.
In food, one such compound is the pigment anthocyanin. Depending on its pH level, anthyocyanins may appear red, purple, blue or black. In nature, the pigment is prevalent with vegetables and grains of these colours, such as blueberries, blackberries, raspberries and strawberries.
Compared to the conventional production of anthocyanin, Pigmentum’s technology can increase the pigment’s production fifteen-fold, we were told.

Another compound under development is vanillin – the primary component of the extract of the vanilla bean. This development is promising, given natural vanillin’s unstable supply chain.
Producing natural vanilla for the food and beverage industry is a time- and labour-intensive process. Pollinating and harvesting the beans is largely conducted by hand in tropical climates, which are increasingly impacted by climate change.
As a result, the majority of ‘vanilla taste’ is synthetic, produced from petrochemical raw materials. Pigmentum’s technology could ease pressure on the natural vanilla supply chain and reduce production of synthetic alternatives.

The start-up is also producing animal-sourced compounds in its transgenic lettuce varieties. The first protein in its sights is the main protein in milk: casein. The protein exists in four subtypes - αs1-casein, αs2-casein, β-casein, and κ-casein – and Pigmentum hopes to commercialise them all for the alternative dairy sector.
Molecular farming vs precision fermentation
A growing number of entrepreneurs are producing these compounds, including pigments and dairy proteins, in the laboratory. Another Israeli start-up, Phytolon, is leveraging precision fermentation technology on yeast strains in bioreactors to produce nature equivalent hues.
Precision fermentation is also popular with dairy. Perfect Day, for example, is already marketing its precision fermentation-derived whey in the US. Other start-ups working on casein include Israel’s Remilk and Imagindairy, and Estonia’s ProProtein.
If bio-equivalent dairy proteins are already being produced in a lab, what are the advantages of producing proteins in transgenic plants?
According to Pigmentum, a major benefit of its molecular farming-based technology compared to precision fermentation lies in capital expenditure. “The upfront investment required to grow the biomass in plants is significantly lower because [to scale], you just need to grow more plants, or in the worst-case, you would need a greenhouse. But it’s not as expensive as big fermenters and [associated] infrastructure.”
Another benefit is its ease of scale. Precision fermentation start-ups acknowledge that achieving scale is a hurdle to commercialisation. In Pigmentum’s case, scale is an advantage, we were told. “Scaling up comes from the seeds, and seed production is very easy. Lettuce produces hundreds of seeds per plant.”
The way the protein ‘folds’ in Pigmentum’s production process is also preferable, we were told. Protein folding is a vital cellular process. In order to function correctly, proteins must be correctly folded into specific, three-dimensional shapes.
“Our technology can perform the accurate folding of proteins, which is crucial for its functions. Plants are much better for this [than precision fermentation techniques].
“When we speak about proteins from mammalian sources, then microorganisms such as yeast or bacteria cannot [enable protein folding] as accurately.”
Another of the key advantages of Pigmentum’s platform is its capability of producing ‘very high yields’ and ‘high transcription rates’ achieved via its inducible expression system.
Challenges and opportunities
Pigmentum is not yet on the market and will need to overcome a couple of hurdles before commercialising its plant-expressed compounds.
In the food industry, Pigmentum’s compounds will be classified as novel foods. They are also genetically modified (GM), a technique that has achieved greater consumer acceptance in the US than in other regions such as Europe. As a result, the start-up is targeting GRAS certification and market entry in the US initially.
“Because we’re using lettuce, and lettuce can be grown in close conditions, we have a very high regulatory advantage,” the co-founder explained. The ‘fear’ with GM is that crops will be grown outdoors and enable ‘flowing genetic contamination’ within the area. Lettuce, however, can be grown in vertical farming systems and greenhouses which prevents against contamination, he explained: “It’s a significant advantage.”

Another potential challenge cited by Lutzky lies in market acceptance, particularly in Europe which has historically been wary of GM technology in food production. But at the end of the day, ‘it’s just lettuce juice’, said the co-founder. “We believe the market will adjust to our offerings, mainly because it is a very sustainable approach to protein production.”
Whether to produce ‘lettuce milk’, pigments, or vanillin, Pigmentum’s production process requires at least five times less land compared to existing alternatives, the co-founder continued. “And if you think that around 80% of grazing land and cropland dedicated to the production of feed, well, we are doing it directly from the plant to the plate or bottle.”

Pigmentum joined the Fresh Start incubator in Northern Israel at the beginning of last year. The start-up predicts its first compound, which will target the pharmaceutical sector, to enter the market mid-2023.
Its first food ingredients will take a little bit longer to reach commercialisation, the co-founder explained, predicting market entry before 2025.